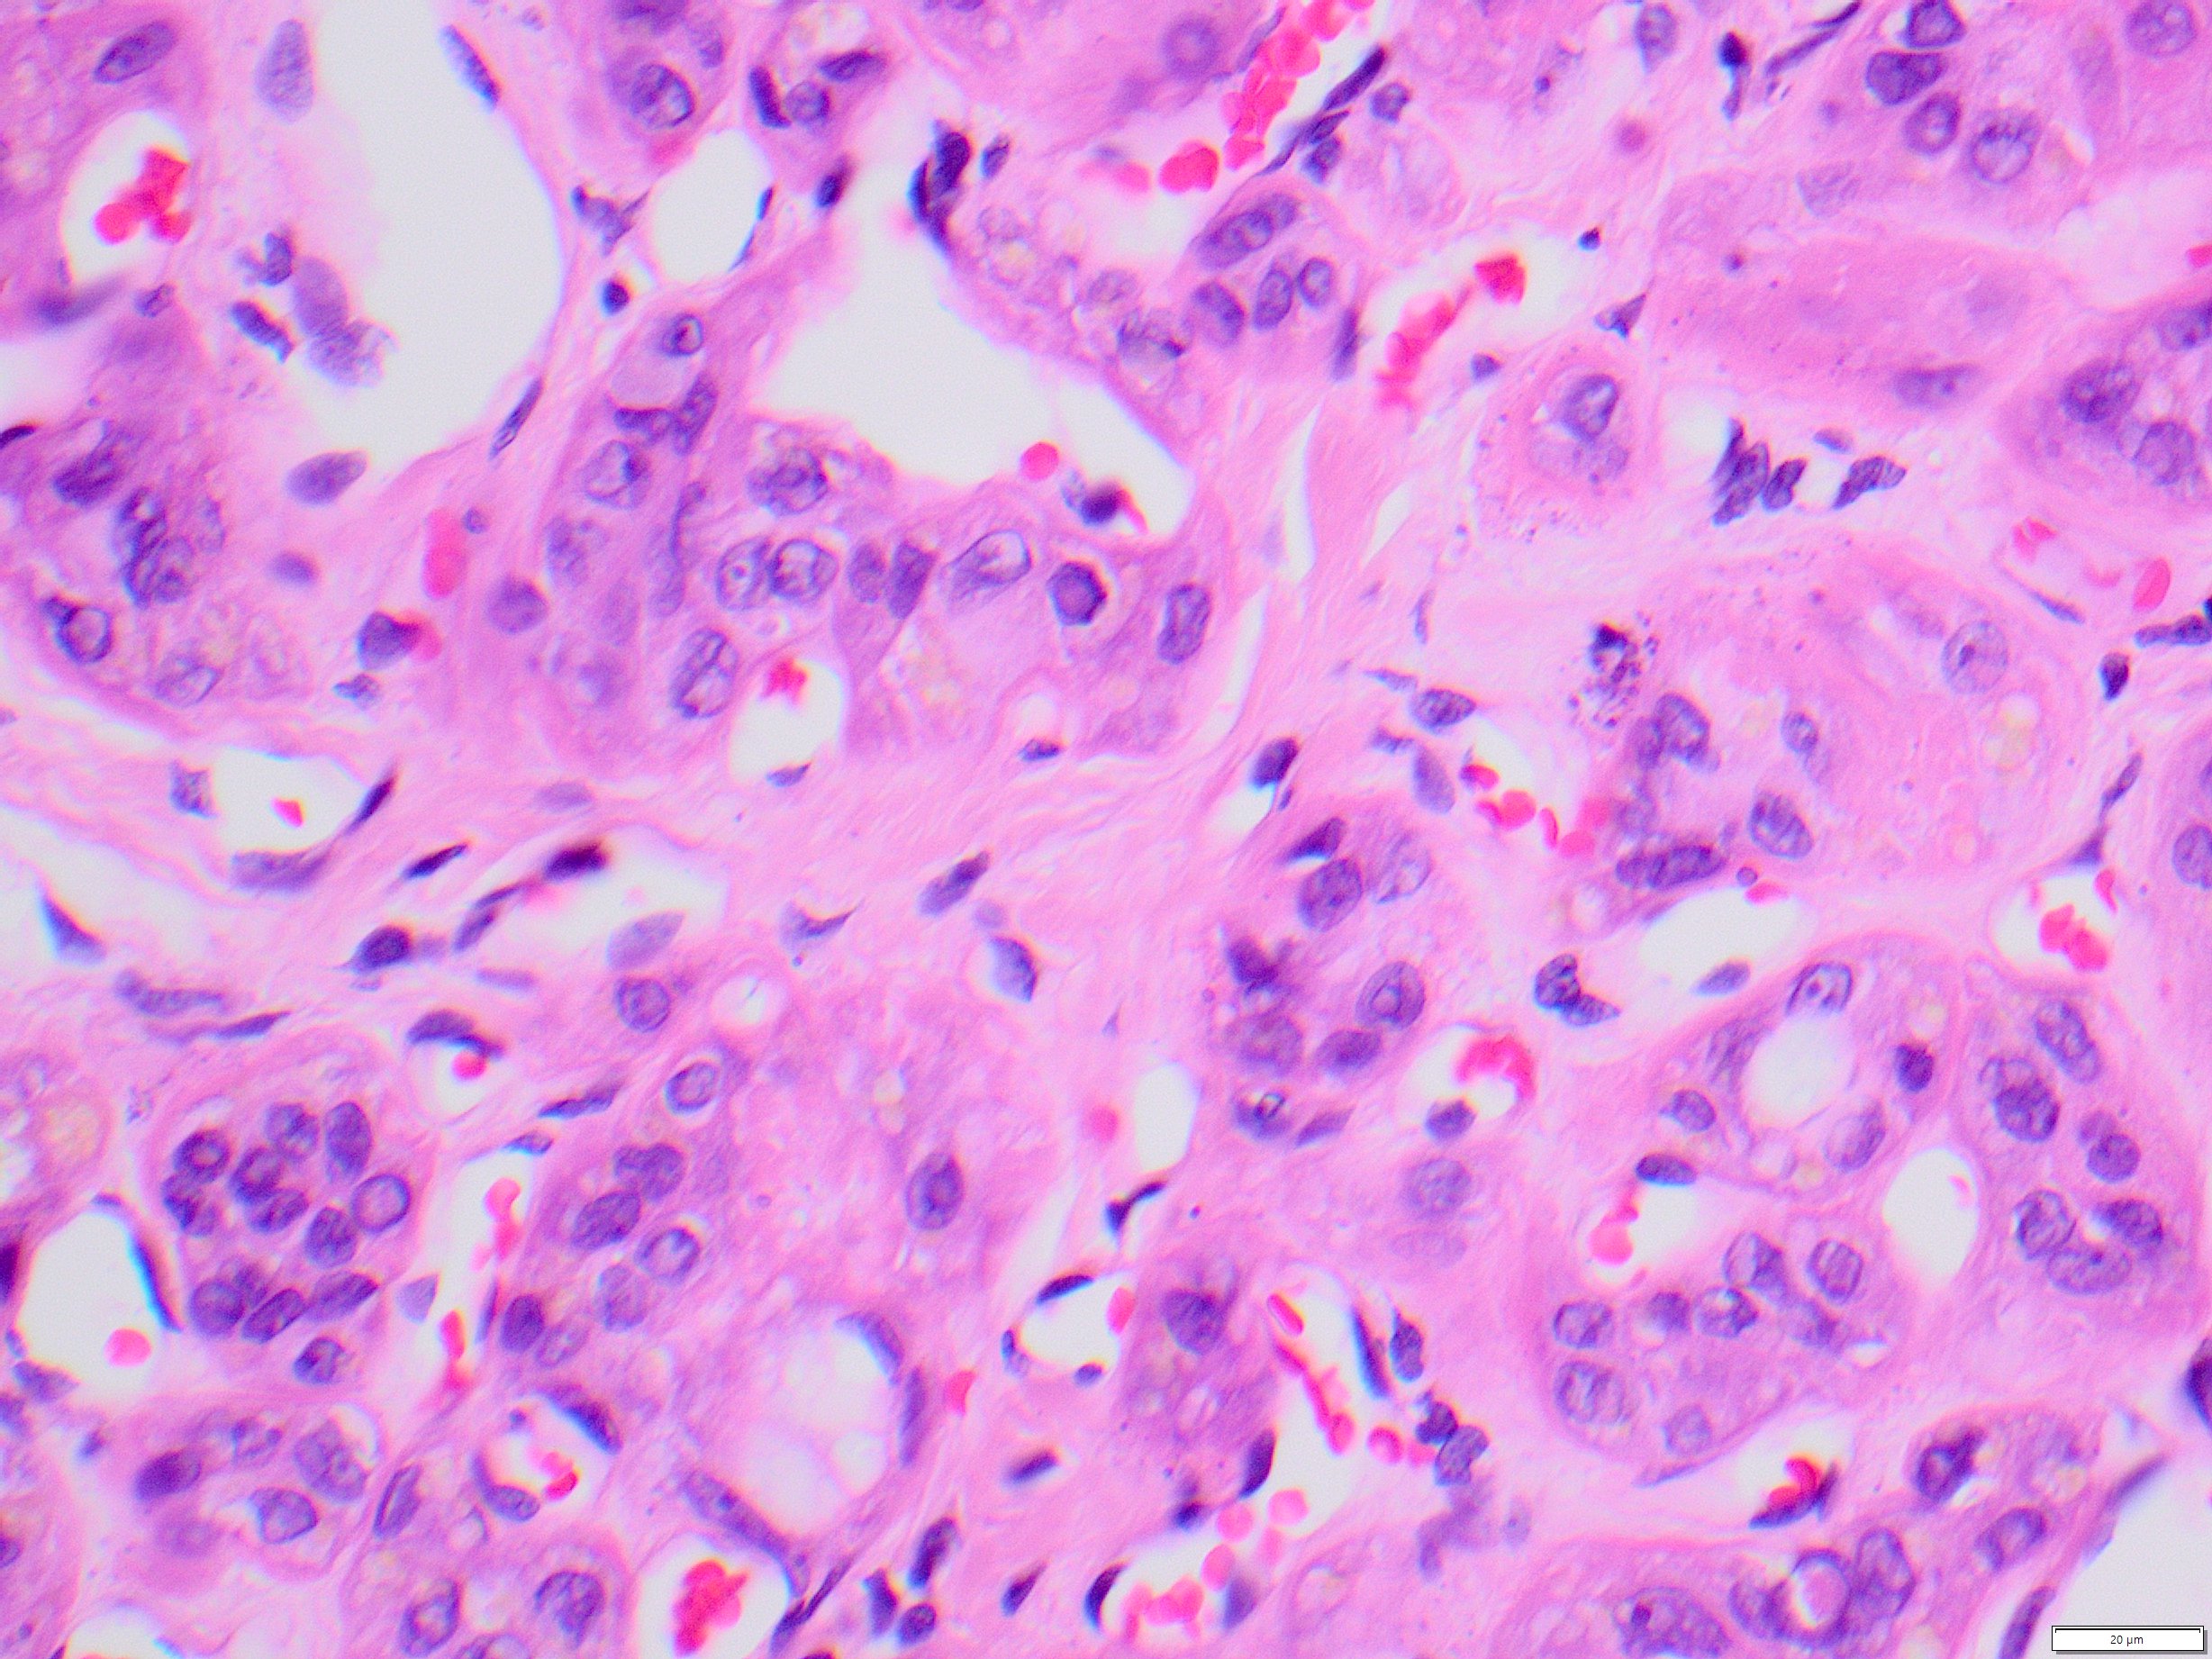
HTT 40x

Case History
A 69-year-old woman presents with a thyroid mass. Representative sections of the thyroidectomy specimen are shown.
What is the most likely molecular abnormality?
- BRAFV600E
- BRAFK601E
- RET/PTC translocation
- TERT promoter mutation
Answer: C. RET/PTC translocation
Brief explanation of the answer:
Sections show a tumor with trabecular and organoid architecture with cystic spaces and prominent fibrovascular stroma. Calcifications are also present. Tumor cells have abundant granular cytoplasm with nuclear grooves, pseudoinclusions, and pale chromatin. Some cells also have yellow cytoplasmic inclusions. These features are consistent with hyalinizing trabecular tumor/adenoma. Though papillary nuclear features are present, these tumors tend to behave as benign neoplasms. RET/PTC translocations have been identified in some of these tumors. However, BRAF mutations have not been found. TERT promoter mutations are strongly associated with malignant neoplasms of the thyroid and confer a poor prognosis.
Case contributed by: Diana Lin, M.D.,Assistant Professor, Anatomic Pathology